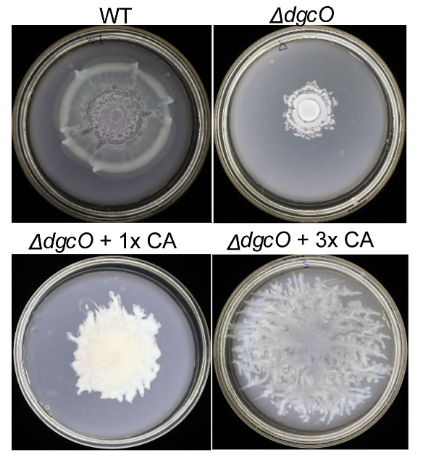
Microbiology Monday: To swim or to swarm? 🦠While c-di-GMP inhibits swimming to promote biofilm formation in E. coli, elevated levels of the secondary message molecule trigger production of a surfactant (colanic acid) that aids swarming. #mBio: asm.social/2pm

Yaoqin Hong
@hyq2015
Bacteriologist and Lecturer @jcu & @jcu_biomedicine. Loves anything bacterial especially cell envelope. The views are all mine.
ID: 3379038437
https://www.researchgate.net/profile/Yaoqin_Hong 16-07-2015 17:07:15
1,1K Tweet
192 Followers
254 Following


Please repost: Postdoc position in antibiotic discovery in a multidisciplinary project w. high-throughput approaches, microscopy, AI, and hit-to-lead optimization Université de Montréal Faculté de médecine Mila - Institut québécois d'IA IRIC. Apply @ [email protected]. See lnkd.in/dVVk4N3s







Out today in Biology Letters - mate copying is not limited to Drosophila melanogaster. It´s sister species D. simulans does it too! We tested females from 3 populations and they all copied. This suggests that this strategy may be more widespread🪰royalsocietypublishing.org/doi/10.1098/rs…











New in #mLife: Yaoqin Hong, Jilong Qin & Makrina Totsika explore how both overly stiff and overly fluid membranes impair biofilm growth in E. coli—revealing a “Goldilocks” fluidity zone. @wileymicrobio 👉doi.org/10.1002/mlf2.7…